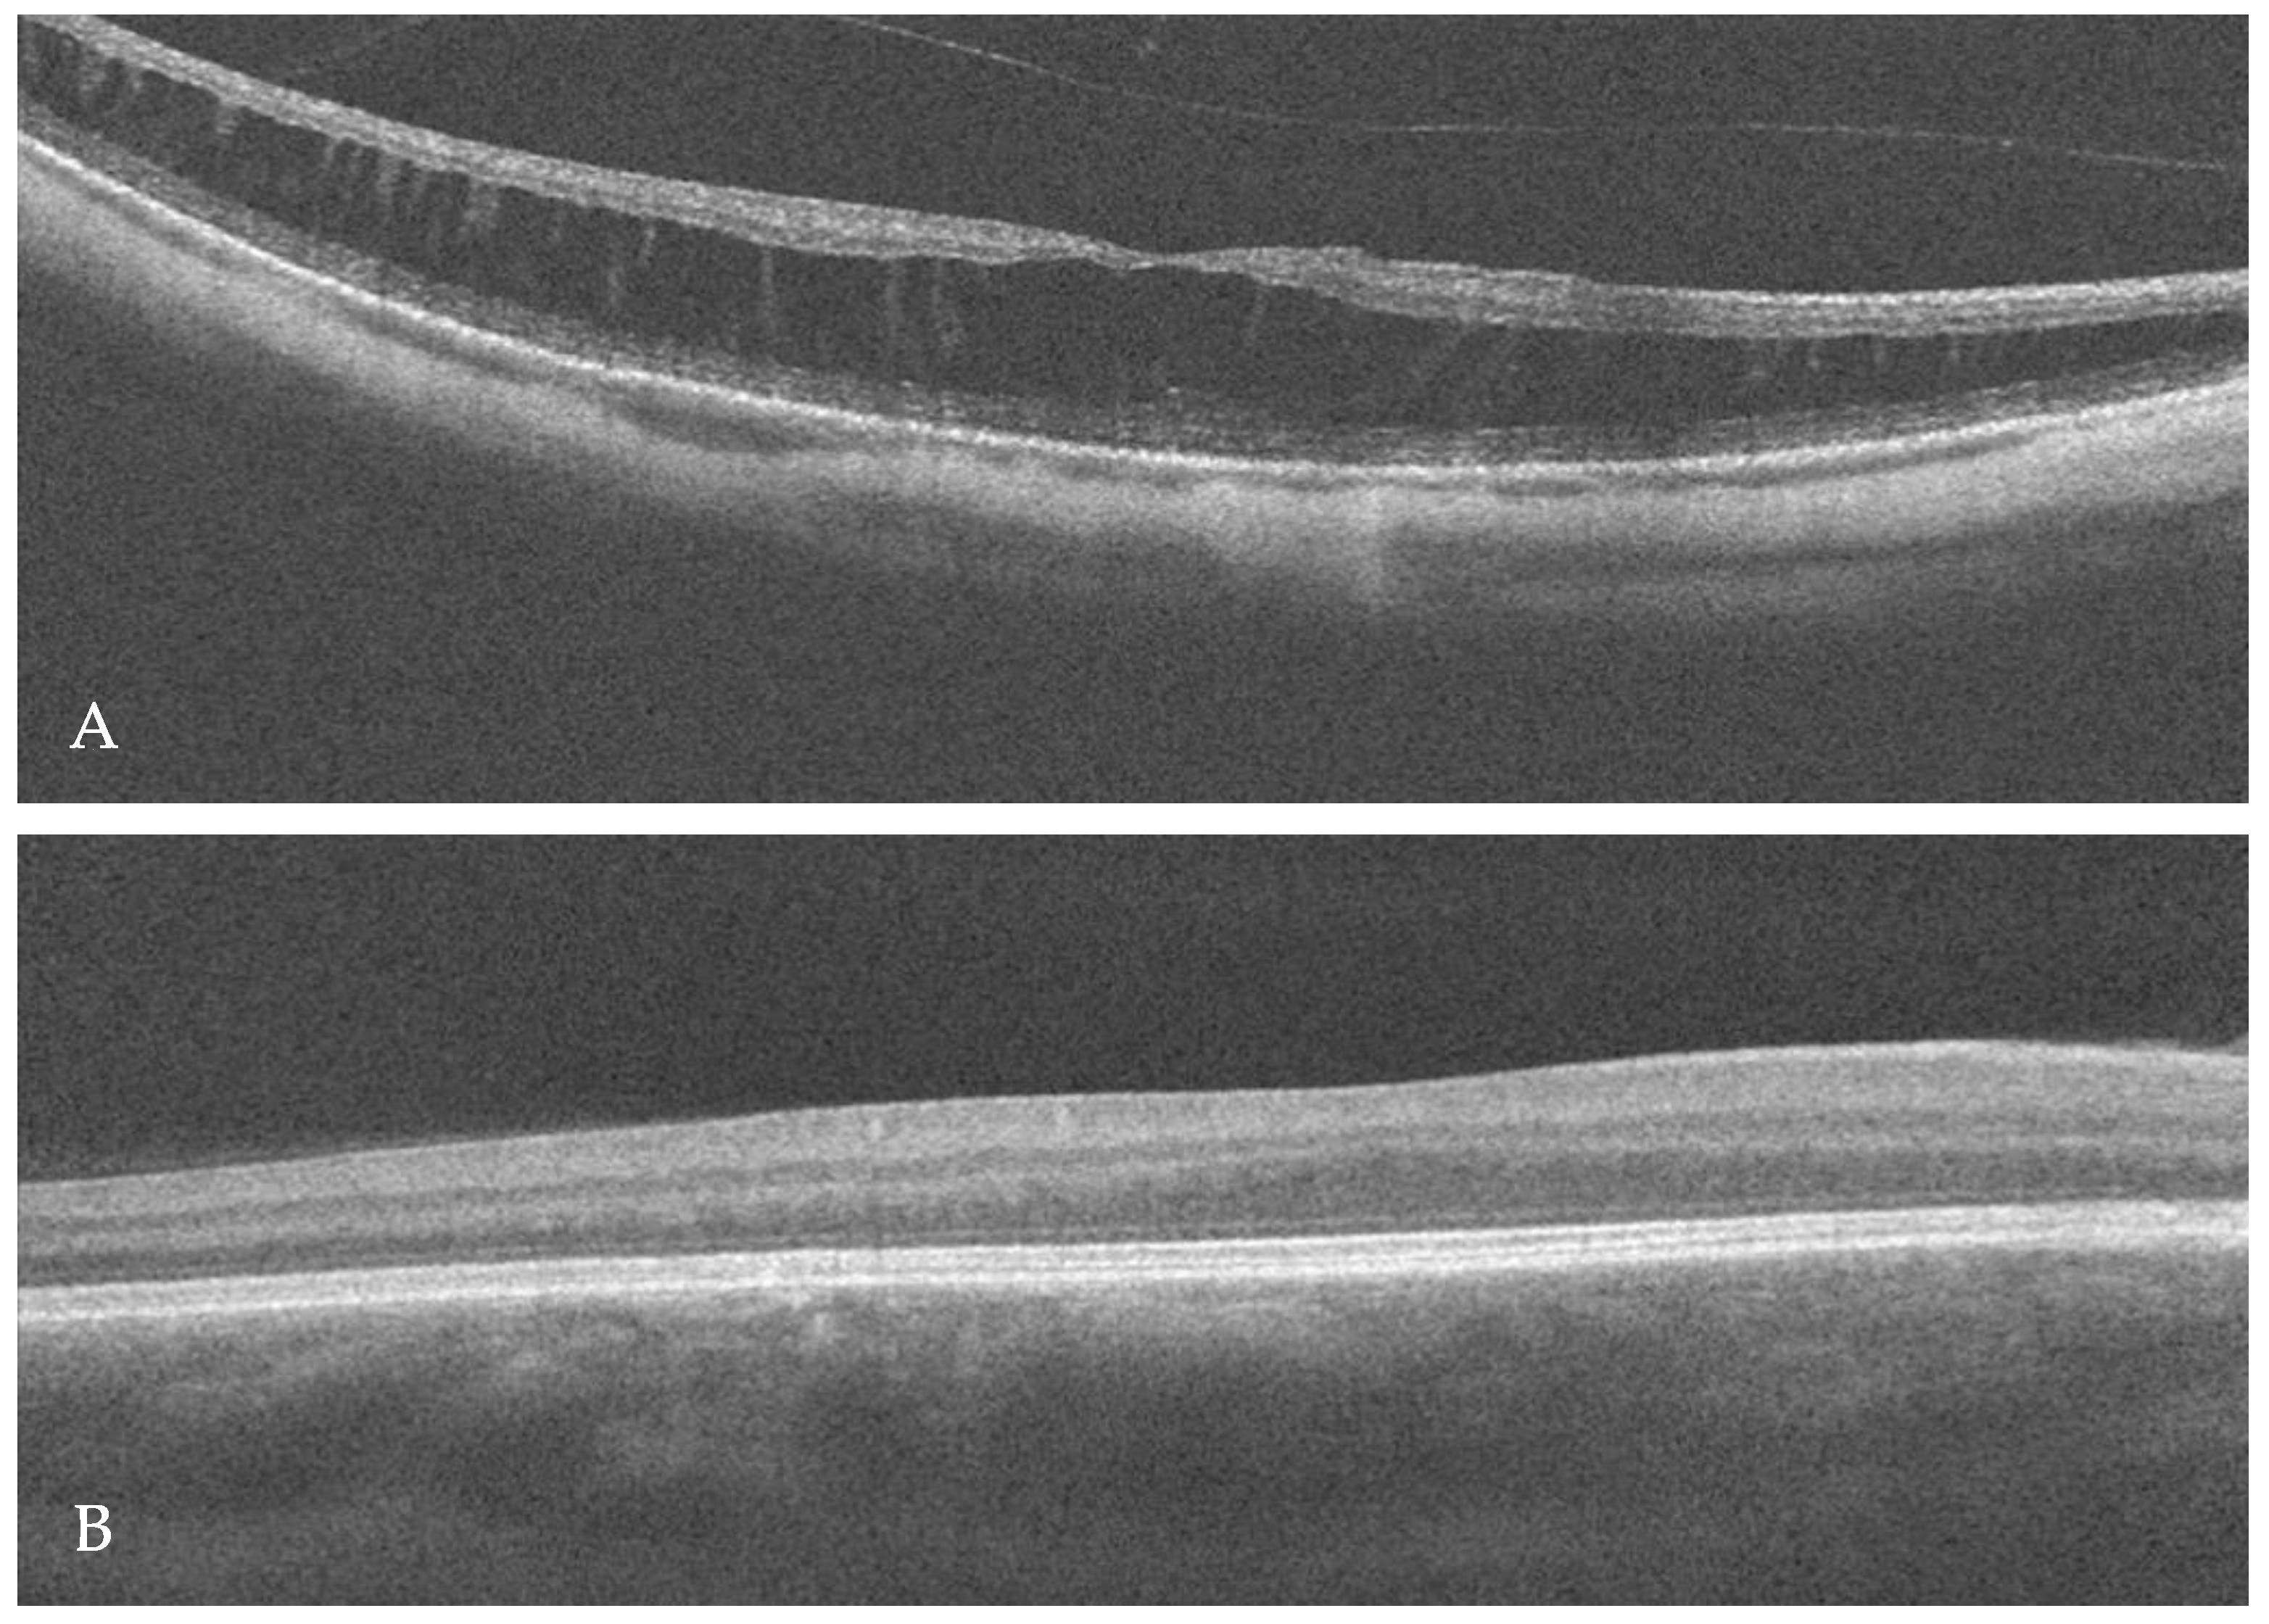
Ijms 25 02928 g002

Aland Island Eye Disease with Retinoschisis in the Clinical Spectrum of CACNA1F-Associated Retinopathy—A Case Report
Abstract
1. Introduction
2. Case Report
3. Discussion
4. Conclusions
Author Contributions
Funding
Institutional Review Board Statement
Informed Consent Statement
Data Availability Statement
Conflicts of Interest
References
- Hove, M.N.; Kilic-Biyik, K.Z.; Trotter, A.; Grønskov, K.; Sander, B.; Larsen, M.; Carroll, J.; Bech-Hansen, T.; Rosenberg, T. Clinical Characteristics, Mutation Spectrum, and Prevalence of Åland Eye Disease/Incomplete Congenital Stationary Night Blindness in Denmark. Investig. Ophthalmol. Vis. Sci. 2016, 57, 6861–6869. [Google Scholar] [CrossRef]
- Jalkanen, R.; Bech-Hansen, N.T.; Tobias, R.; Sankila, E.M.; Mäntyjärvi, M.; Forsius, H.; de la Chapelle, A.; Alitalo, T. A novel CACNA1F gene mutation causes Aland Island eye disease. Investig. Ophthalmol. Vis. Sci. 2007, 48, 2498–2502. [Google Scholar] [CrossRef]
- De Silva, S.R.; Arno, G.; Robson, A.G.; Fakin, A.; Pontikos, N.; Mohamed, M.D.; Bird, A.C.; Moore, A.T.; Michaelides, M.; Webster, A.R.; et al. The X-linked retinopathies: Physiological insights, pathogenic mechanisms, phenotypic features and novel therapies. Prog. Retin. Eye Res. 2021, 82, 100898. [Google Scholar] [CrossRef] [PubMed]
- van Vliet, A.G.; Waardenburg, P.J.; Forsius, H.; Eriksson, A.W. Nystagmographical studies in Aland eye disease. Acta Ophthalmol. 1973, 51, 782–790. [Google Scholar] [CrossRef] [PubMed]
- O’Donnell, F.E.; Green, W.R.; McKusick, V.A.; Forsius, H.; Eriksson, A.W. Forsius-Eriksson syndrome: Its relation to the Nettleship-Falls X-linked ocular albinism. Clin. Genet. 1980, 17, 403–408. [Google Scholar] [CrossRef] [PubMed]
- van Dorp, D.B.; Eriksson, A.W.; Delleman, J.W.; van Vliet, A.G.; Collewijn, H.; van Balen, A.T.; Forsius, H.R. Aland eye disease: No albino misrouting. Clin. Genet. 1985, 28, 526–531. [Google Scholar] [CrossRef]
- Michalakis, S.; Shaltiel, L.; Sothilingam, V.; Koch, S.; Schludi, V.; Krause, S.; Zeitz, C.; Audo, I.; Lancelot, M.E.; Hamel, C.; et al. Mosaic synaptopathy and functional defects in Cav1.4 heterozygous mice and human carriers of CSNB2. Hum. Mol. Genet. 2014, 23, 1538–1550. [Google Scholar] [CrossRef] [PubMed]
- McRory, J.E.; Hamid, J.; Doering, C.J.; Garcia, E.; Parker, R.; Hamming, K.; Chen, L.; Hildebrand, M.; Beedle, A.M.; Feldcamp, L.; et al. The CACNA1F gene encodes an L-type calcium channel with unique biophysical properties and tissue distribution. J. Neurosci. 2004, 24, 1707–1718. [Google Scholar] [CrossRef] [PubMed]
- Baumann, L.; Gerstner, A.; Zong, X.; Biel, M.; Wahl-Schott, C. Functional characterization of the L-type Ca2+ channel Cav1.4alpha1 from mouse retina. Investig. Ophthalmol. Vis. Sci. 2004, 45, 708–713. [Google Scholar] [CrossRef]
- Koschak, A.; Fernandez-Quintero, M.L.; Heigl, T.; Ruzza, M.; Seitter, H.; Zanetti, L. Cav1.4 dysfunction and congenital stationary night blindness type 2. Pflugers Arch. 2021, 473, 1437–1454. [Google Scholar] [CrossRef]
- Zeitz, C.; Robson, A.G.; Audo, I. Congenital stationary night blindness: An analysis and update of genotype-phenotype correlations and pathogenic mechanisms. Prog. Retin. Eye Res. 2015, 45, 58–110. [Google Scholar] [CrossRef] [PubMed]
- Mahmood, U.; Méjécase, C.; Ali, S.M.A.; Moosajee, M.; Kozak, I. A Novel Splice-Site Variant in CACNA1F Causes a Phenotype Synonymous with Åland Island Eye Disease and Incomplete Congenital Stationary Night Blindness. Genes 2021, 12, 171. [Google Scholar] [CrossRef] [PubMed]
- Jalkanen, R.; Mäntyjärvi, M.; Tobias, R.; Isosomppi, J.; Sankila, E.M.; Alitalo, T.; Bech-Hansen, N.T. X linked cone-rod dystrophy, CORDX3, is caused by a mutation in the CACNA1F gene. J. Med. Genet. 2006, 43, 699–704. [Google Scholar] [CrossRef] [PubMed]
- Odom, J.V.; Bach, M.; Brigell, M.; Holder, G.E.; McCulloch, D.L.; Mizota, A.; Tormene, A.P. International Society for Clinical Electrophysiology of Vision. ISCEV standard for clinical visual evoked potentials: (2016 update). Doc. Ophthalmol. 2016, 133, 77. [Google Scholar] [CrossRef] [PubMed]
- Robson, A.G.; Frishman, L.J.; Grigg, J.; Hamilton, R.; Jeffrey, B.G.; Kondo, M.; Li, S.; McCulloch, D.L. ISCEV Standard for full-field clinical electroretinography (2022 update). Doc. Ophthalmol. 2022, 144, 165–177. [Google Scholar] [CrossRef] [PubMed]
- Takahashi, M.; Seagar, M.J.; Jones, J.F.; Reber, B.F.; Catterall, W.A. Subunit structure of dihydropyridine-sensitive calcium channels from skeletal muscle. Proc. Natl. Acad. Sci. USA 1987, 84, 5478–5482. [Google Scholar] [CrossRef]
- Koschak, A.; Reimer, D.; Walter, D.; Hoda, J.C.; Heinzle, T.; Grabner, M.; Striessnig, J. Cav1.4alpha1 subunits can form slowly inactivating dihydropyridine-sensitive L-type Ca2+ channels lacking Ca2+-dependent inactivation. J. Neurosci. 2003, 23, 6041–6049. [Google Scholar] [CrossRef]
- Singh, A.; Hamedinger, D.; Hoda, J.C.; Gebhart, M.; Koschak, A.; Romanin, C.; Striessnig, J. C-terminal modulator controls Ca2+-dependent gating of Ca(v)1.4 L-type Ca2+ channels. Nat. Neurosci. 2006, 9, 1108–1116. [Google Scholar] [CrossRef]
- Liu, X.; Kerov, V.; Haeseleer, F.; Majumder, A.; Artemyev, N.; Baker, S.A.; Lee, A. Dysregulation of Ca(v)1.4 channels disrupts the maturation of photoreceptor synaptic ribbons in congenital stationary night blindness type 2. Channels 2013, 7, 514–523. [Google Scholar] [CrossRef]
- Maddox, J.W.; Randall, K.L.; Yadav, R.P.; Williams, B.; Hagen, J.; Derr, P.J.; Kerov, V.; Della Santina, L.; Baker, S.A.; Artemyev, N.; et al. A dual role for Cav1.4 Ca2+ channels in the molecular and structural organization of the rod photoreceptor synapse. eLife 2020, 9, e62184. [Google Scholar] [CrossRef]
- Gupta, S.K.; Chakraborty, R.; Verkicharla, P.K. Electroretinogram responses in myopia: A review. Doc. Ophthalmol. 2022, 2, 77–95. [Google Scholar] [CrossRef]
- Sin, T.N.; Kim, S.; Li, Y.; Wang, J.; Chen, R.; Chung, S.H.; Kim, S.; Casanova, M.I.; Park, S.; Smit-McBride, Z.; et al. A Spontaneous Nonhuman Primate Model of Myopic Foveoschisis. Investig. Ophthalmol. Vis. Sci. 2023, 64, 18. [Google Scholar] [CrossRef] [PubMed]
- Shi, L.; Ko, M.L.; Ko, G.Y. Retinoschisin Facilitates the Function of L-Type Voltage-Gated Calcium Channels. Front. Cell. Neurosci. 2017, 11, 232. [Google Scholar] [CrossRef]
- Weber, B.H.; Schrewe, H.; Molday, L.L.; Gehrig, A.; White, K.L.; Seeliger, M.W.; Jaissle, G.B.; Friedburg, C.; Tamm, E.; Molday, R.S. Inactivation of the murine X-linked juvenile retinoschisis gene, Rs1h, suggests a role of retinoschisin in retinal cell layer organization and synaptic structure. Proc. Natl. Acad. Sci. USA 2002, 99, 6222–6227. [Google Scholar] [CrossRef]
- Ko, M.L.; Liu, Y.; Shi, L.; Trump, D.; Ko, G.Y. Circadian regulation of retinoschisin in the chick retina. Investig. Ophthalmol. Vis. Sci. 2008, 49, 1615–1621. [Google Scholar] [CrossRef]
- Shi, L.; Jian, K.; Ko, M.L.; Trump, D.; Ko, G.Y. Retinoschisin, a new binding partner for L-type voltage-gated calcium channels in the retina. J. Biol. Chem. 2009, 284, 3966–3975. [Google Scholar] [CrossRef] [PubMed]
- Boycott, K.M.; Pearce, W.G.; Bech-Hansen, N.T. Clinical variability among patients with incomplete X-linked congenital stationary night blindness and a founder mutation in CACNA1F. Can. J. Ophthalmol. 2000, 35, 204–213. [Google Scholar] [CrossRef] [PubMed]
- Mihalich, A.; Cammarata, G.; Tremolada, G.; Pollazzon, M.; Di Blasio, A.M.; Marzoli, S.B. Two novel CACNA1F gene mutations cause two different phenotypes: Aland Eye Disease and incomplete Congenital Stationary Night Blindness. Exp. Eye Res. 2022, 221, 109143. [Google Scholar] [CrossRef]
- Burtscher, V.; Schicker, K.; Novikova, E.; Pöhn, B.; Stockner, T.; Kugler, C.; Singh, A.; Zeitz, C.; Lancelot, M.E.; Audo, I.; et al. Spectrum of Cav1.4 dysfunction in congenital stationary night blindness type 2. Biochim. Biophys. Acta 2014, 8, 2053–2065. [Google Scholar] [CrossRef]
- Vincent, A.; Wright, T.; Day, M.A.; Westall, C.A.; Héon, E. A novel p.Gly603Arg mutation in CACNA1F causes Åland island eye disease and incomplete congenital stationary night blindness phenotypes in a family. Mol. Vis. 2011, 17, 3262–3270. [Google Scholar]
- Hope, C.I.; Sharp, D.M.; Hemara-Wahanui, A.; Sissingh, J.I.; Lundon, P.; Mitchell, E.A.; Maw, M.A.; Clover, G.M. Clinical manifestations of a unique X-linked retinal disorder in a large New Zealand family with a novel mutation in CACNA1F, the gene responsible for CSNB2. Clin. Exp. Ophthalmol. 2005, 33, 129–136. [Google Scholar] [CrossRef] [PubMed]
- Nakamura, M.; Ito, S.; Piao, C.H.; Terasaki, H.; Miyake, Y. Retinal and optic disc atrophy associated with a CACNA1F mutation in a Japanese family. Arch. Ophthalmol. 2003, 121, 1028–1033. [Google Scholar] [CrossRef] [PubMed]
- Urnov, F.D.; Rebar, E.J.; Holmes, M.C.; Zhang, H.S.; Gregory, P.D. Genome editing with engineered zinc finger nucleases. Nat. Rev. Genet. 2010, 9, 636–646. [Google Scholar] [CrossRef] [PubMed]
- Wright, D.A.; Li, T.; Yang, B.; Spalding, M.H. TALEN-mediated genome editing: Prospects and perspectives. Biochem. J. 2014, 462, 15–24. [Google Scholar] [CrossRef]
- Hirakawa, M.P.; Krishnakumar, R.; Timlin, J.A.; Carney, J.P.; Butler, K.S. Gene editing and CRISPR in the clinic: Current and future perspectives. Biosci. Rep. 2020, 40, BSR20200127. [Google Scholar] [CrossRef]
- Waldner, D.M.; Ito, K.; Chen, L.L.; Nguyen, L.; Chow, R.L.; Lee, A.; Rancourt, D.E.; Tremblay, F.; Stell, W.K.; Bech-Hansen, N.T. Transgenic Expression of Cacna1f Rescues Vision and Retinal Morphology in a Mouse Model of Congenital Stationary Night Blindness 2A (CSNB2A). Transl. Vis. Sci. Technol. 2020, 11, 19. [Google Scholar] [CrossRef]
- Laird, J.G.; Gardner, S.H.; Kopel, A.J.; Kerov, V.; Lee, A.; Baker, S.A. Rescue of Rod Synapses by Induction of Cav Alpha 1F in the Mature Cav1.4 Knock-Out Mouse Retina. Investig. Ophthalmol. Vis. Sci. 2019, 8, 3150–3161. [Google Scholar] [CrossRef]

Disclaimer/Publisher’s Note: The statements, opinions and data contained in all publications are solely those of the individual author(s) and contributor(s) and not of MDPI and/or the editor(s). MDPI and/or the editor(s) disclaim responsibility for any injury to people or property resulting from any ideas, methods, instructions or products referred to in the content. |
© 2024 by the authors. Licensee MDPI, Basel, Switzerland. This article is an open access article distributed under the terms and conditions of the Creative Commons Attribution (CC BY) license (https://creativecommons.org/licenses/by/4.0/).
Share and Cite
Wyględowska-Promieńska, D.; Świerczyńska, M.; Śpiewak, D.; Pojda-Wilczek, D.; Tronina, A.; Dorecka, M.; Smędowski, A. Aland Island Eye Disease with Retinoschisis in the Clinical Spectrum of CACNA1F-Associated Retinopathy—A Case Report. Int. J. Mol. Sci. 2024, 25, 2928. https://doi.org/10.3390/ijms25052928
Wyględowska-Promieńska D, Świerczyńska M, Śpiewak D, Pojda-Wilczek D, Tronina A, Dorecka M, Smędowski A. Aland Island Eye Disease with Retinoschisis in the Clinical Spectrum of CACNA1F-Associated Retinopathy—A Case Report. International Journal of Molecular Sciences. 2024; 25(5):2928. https://doi.org/10.3390/ijms25052928
Chicago/Turabian StyleWyględowska-Promieńska, Dorota, Marta Świerczyńska, Dorota Śpiewak, Dorota Pojda-Wilczek, Agnieszka Tronina, Mariola Dorecka, and Adrian Smędowski. 2024. "Aland Island Eye Disease with Retinoschisis in the Clinical Spectrum of CACNA1F-Associated Retinopathy—A Case Report" International Journal of Molecular Sciences 25, no. 5: 2928. https://doi.org/10.3390/ijms25052928
APA StyleWyględowska-Promieńska, D., Świerczyńska, M., Śpiewak, D., Pojda-Wilczek, D., Tronina, A., Dorecka, M., & Smędowski, A. (2024). Aland Island Eye Disease with Retinoschisis in the Clinical Spectrum of CACNA1F-Associated Retinopathy—A Case Report. International Journal of Molecular Sciences, 25(5), 2928. https://doi.org/10.3390/ijms25052928




